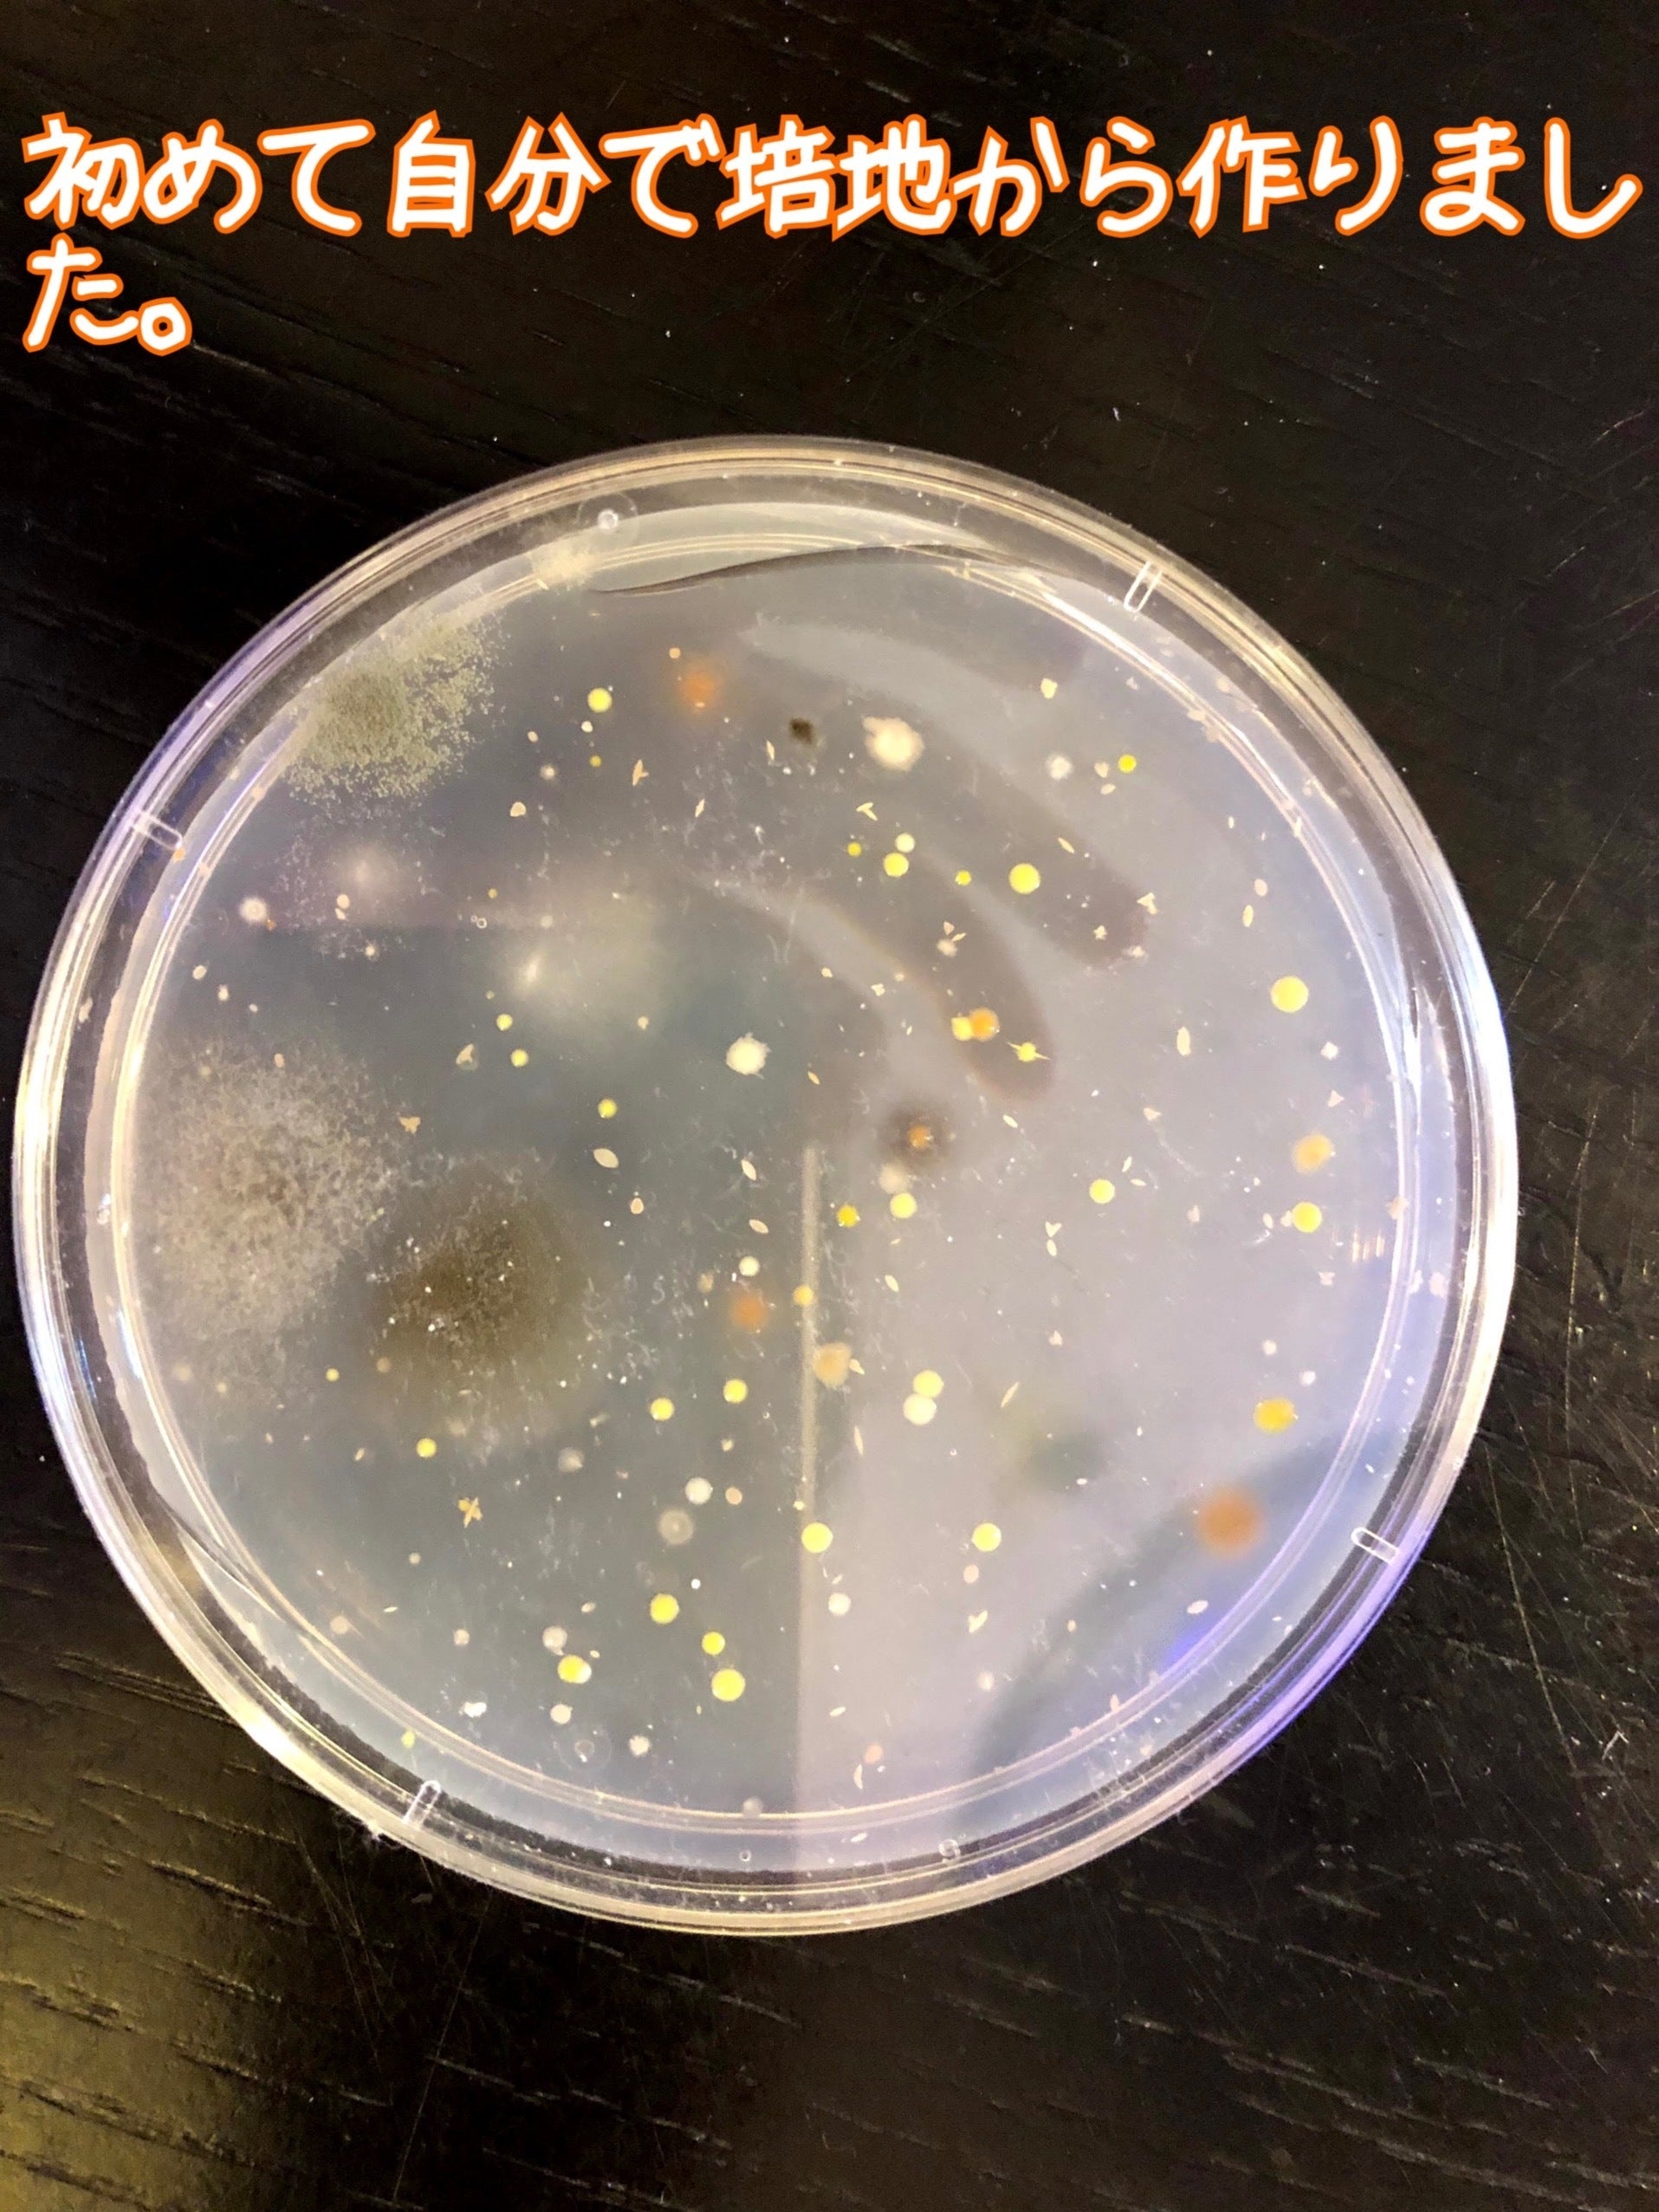

はじめに・ご挨拶
はじめまして!私は小学5年生の女の子です。4年生から不登校になり、今はホームスクーリングで学んでいます。
研究やパソコンをいじること、読書が好きです。今は「酸性湖や汽水に生息する微生物」というテーマで研究をしています。
勉強が好きなのですが、気づいたら学校の授業が合わなくなっていました。家では、高校数学や生物・化学なんかを勉強しています。宇宙のことを学ぶのも好きです。
ホームスクーラーになってから時間ができたので、自分の好きなことや気になったこと、いろんなことに挑戦する日々を送っています。

小笠原諸島の海水をフリースクールの顕微鏡を借りて発見したプランクトンです。
このプロジェクトで実現したいこと
最終的なゴールとして、地球の環境問題を解決したいと思っています。
微生物が絶滅危機にある動物などを助けられたり、木が一生の間に吸収できる二酸化炭素の量を増やしたりできないか思っています。
発見されていない微生物が実はたくさんいるということを知り、こういうことを思うようになりました。
プロジェクトをやろうと思った理由
フリースクールで研究のための器具を借りてやっていますが、自宅でも研究をやりたいと思っています。必要な実験器具が足りないので、それを買うためにご支援していただけたらと思って始めました。父と母には主に本を買ってもらっていて、コロナで収入が減った父、学校に行かなくなった私に付き添うため仕事ができなくなった母に、大きな金額のものを頼めずにいます。クラウドファンディングの存在を父から聞き、挑戦してみることにしました。
これまでの活動
DNAについて学んだり、カビについて学んでいました。光る微生物を培養したくて、イカからとったつもりでしたが、これは失敗に終わりました。
研究以外は、色んな検定を受けています。数学検定3級や生物検定2級を持っています。数学検定は準2級を小5のうちにとるつもりです。
資金の使い道
顕微鏡を買うことに使わせていただきます。
リターンについて
お礼のメールを送らせていただきます。研究がうまくいった場合は、レポートも送らせていただきます。
最後に
「子供には学ぶ権利がある」のに、学校に行っていても、勉強に関して自分には学んでる感覚がありませんでした。知っていることが多くて、じっと座って待っていることがしんどかったです。最初は、みんなも同じ気持ちで我慢しているんだと思っていましたが、そうじゃないことを知って、学ぶ場所を変えようと思いました。母はそのことに反対せず、応援してくれています。父も、最初は学校でしか学べないものがあるからと、学校に行くことをすすめてきましたが、今は見守ってくれています。まだ10才なので、お金の面では両親の力を借りなくてはいけませんが、自分でお金を作る力もつけていきたいと思っています。まずは、ここから挑戦します。
<All-or-Nothing方式で行います>
本プロジェクトはAll-or-Nothing方式で実施します。目標金額に満たない場合、計画の実行及びリターンのお届けはございません。来年のお年玉が入るのを待ちます!
最新の活動報告
もっと見る購入しました!
2020/10/03 14:59こちらの活動報告は支援者限定の公開です。
ミジンコ
2020/08/01 08:52顕微鏡でみたいと思っているミジンコを育て始めました!カルキ抜きした水と、ミジンコを持って帰って来るときに使った植物プランクトンが入った水とを混ぜた水のなかで生きてもらっています。栄養分がいるのかなと土をいれたのですが、なかなか濁りがとれなかったのでコーヒーフィルターでろ過しました。その水の中には土の栄養分が入っているかもしれません。 もっと見る
プランクトンネットを手作りしました!
2020/07/20 18:19思ったよりプランクトンが捕まらなくて、プランクトンネットを手作りしました!買うと、二万円ぐらいするのですが、100均でそろえたので千円しかかかりませんでした! もっと見る

コメント
もっと見る